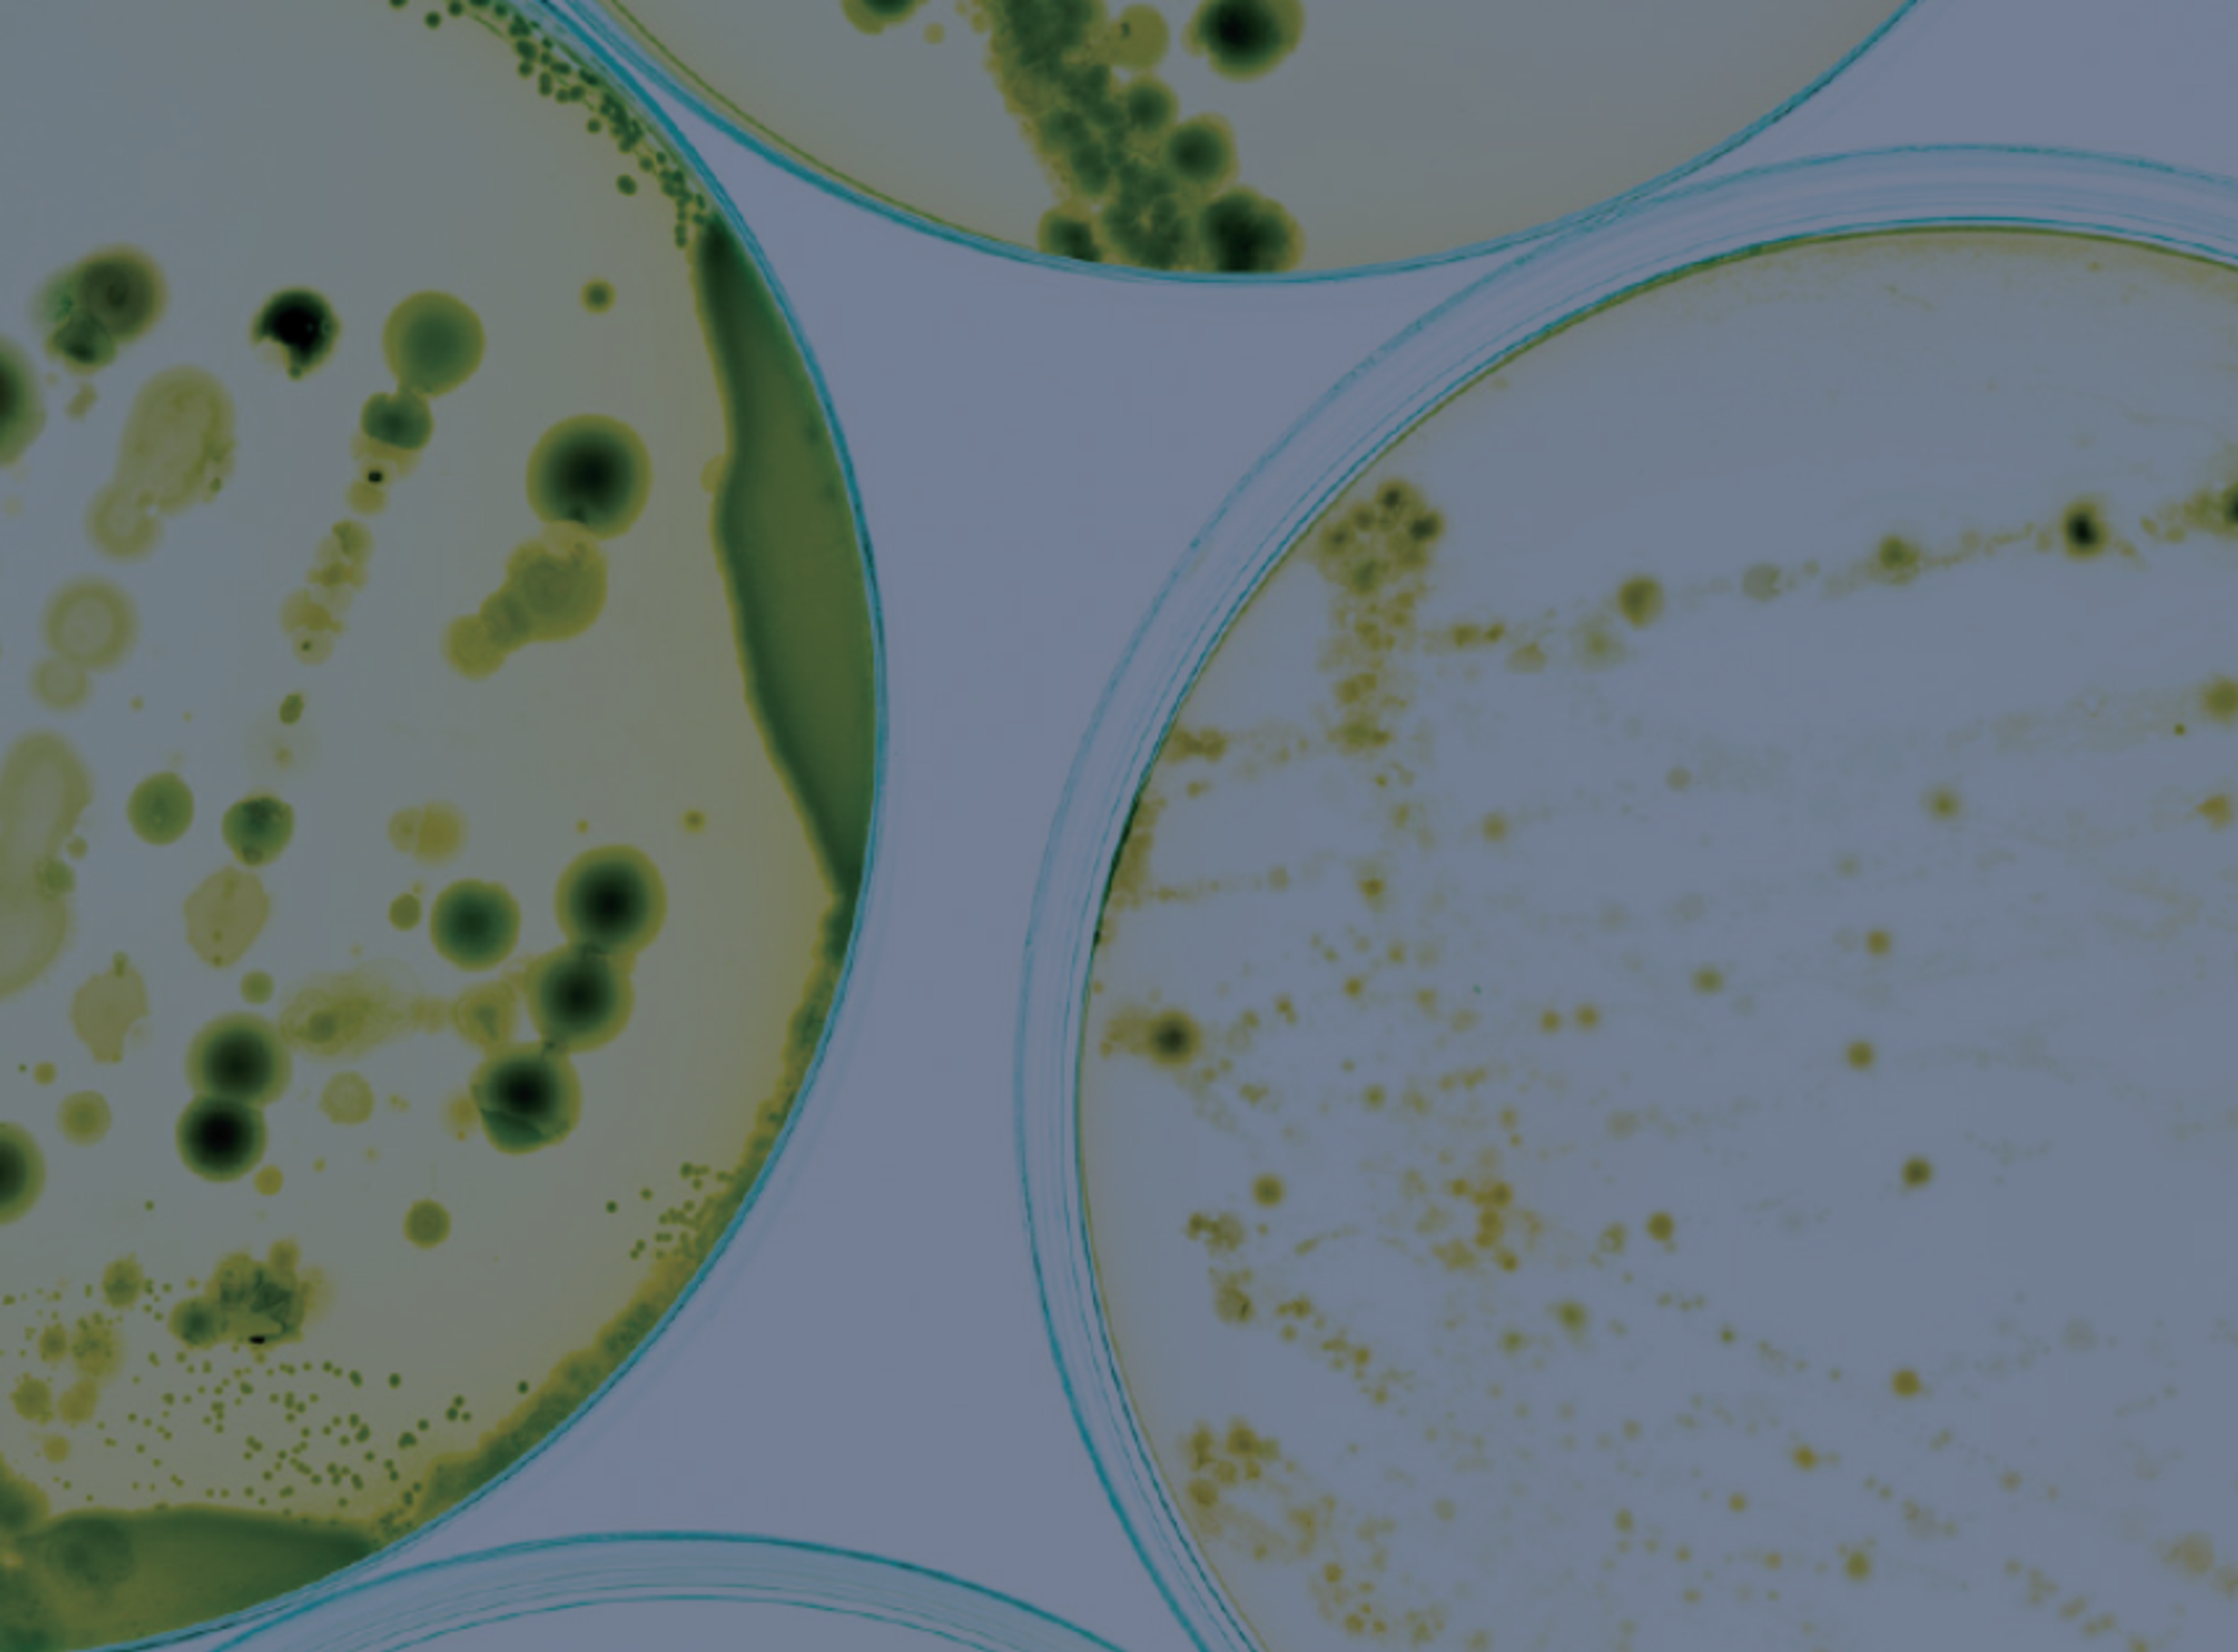

Search results for "eppendorf"
Selected Filters:
Detecting sepsis in the ventilated patient
Data, AI, and predictive modelling in sepsis
Sepsis subtyping with precision medicine
Rapid phenotypic AST for Gram-negative bacteria
How does hypervolemia increase the mortality risk in sepsis?
Closing the needs in pediatric sepsis
Personalized approaches to sepsis management
Challenges and solutions for early recognition and treatment of sepsis
The need for early diagnosis and treatment of sepsis in surgical patients
Your guide to nucleic acid quantification
From absorbance to fluorescence, this eBook provides an in-depth guide to selecting the best tools and methods for nucleic acid quantification
Bio-Rad launches Nuvia wPrime 2A Media for biomolecule purification
Unlock small to large scale purification using weak anion exchange and hydrophobic interaction (AEX-HIC) mixed-mode chromatography resin innovation
PAT-enabled scaling and optimization of upstream bioprocesses
Precision and efficiency with AI-enhanced cell counting
Aiosyn Mitosis Breast becomes the first AI-powered mitosis detection solution to achieve CE mark certification under IVDR
Enhancing breast cancer diagnostics with precision, efficiency, and improved grading consistency for better patient outcomes
AI confluency analysis for enhanced precision in 2D cell culture
Leveraging AI for efficient analysis of cell transfection
bioMérieux expands point-of-care diagnostics with SpinChip acquisition
This innovative technology aims to improve acute care outcomes, particularly for myocardial infarction diagnosis.
PacBio’s HiFi sequencing technology delivers promising results for rare disease diagnostics in partnership with Radboud UMC
Study shows PacBio's HiFi long-read sequencing can identify genetic causes of rare diseases, potentially simplifying diagnostics
The medieval pandemic that never really went away
Scripps Research scientists create AI that 'watches' videos by mimicking the brain
A new, more sustainable AI model recognizes visual scenes by mirroring brain processes, opening doors for applications in medical diagnostics, drug discovery and beyond
What’s behind today’s clinical laboratory staffing shortage?
Burnout and other factors are hitting clinical laboratories hard, what’s driving the shortfall of lab techs, and what can be done to reverse the trend?
Spear Bio's pTau 217 blood test earns FDA breakthrough designation
Advancing early Alzheimer's diagnosis with scalable, ultra-sensitive technology